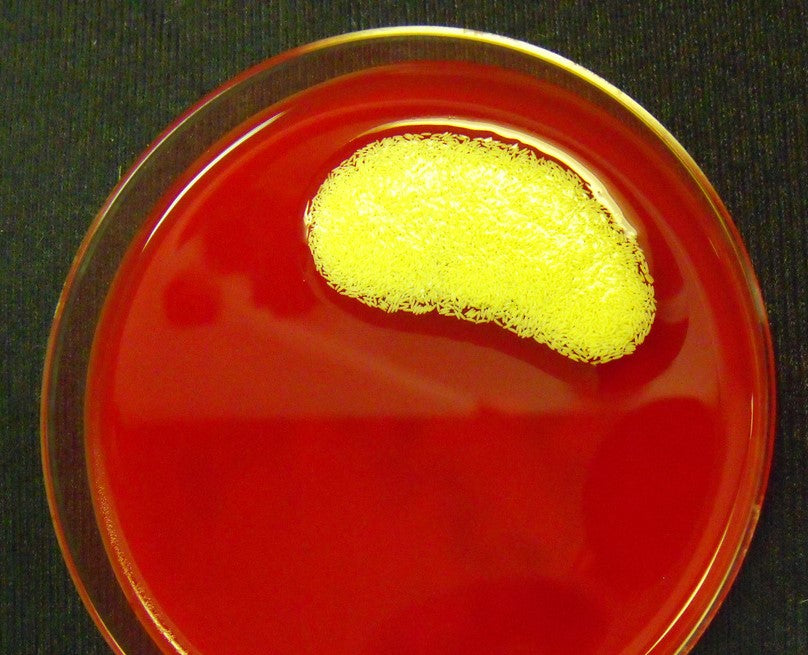
Larval Therapy
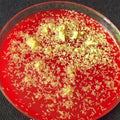
Larval Therapy
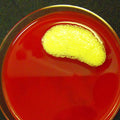
Larval Therapy

Larval Therapy
SoundHorse utilizes the common green bottle fly larvae (Phaenicia sericata) to aid in the removal of devitalized and necrotic tissue and reduce the growth of harmful bacteria. These larvae have the unique ability to remove only devitalized tissue, leaving healthy tissue behind. In addition to larval therapy’s effective debridement capabilities, they are also known to stimulate healing through secreted growth factors that aid in the formation of granulation tissue and neovascularization. This product is commonly used with a hospital treatment plate.
Conditions where larval therapy has been used: septic pedal osteitis, fistulous withers, postsurgical abdominal dehiscence, foot abscesses, frog abscesses, quittor, osteomyelitis, and navicular bursa sepsis.
Size: Each vial contains 500 – 1000 viable larvae.
Please read shipping information carefully. Larvae will ONLY ship Monday through Thursday via FedEx (not UPS) and will arrive the next day. Orders must be placed by 2 PM to ship same day. Please call our office with any questions or to check on availability (800) 801-2654.
Vials are shipped overnight with a cooler pack. Upon arrival, the vial should be kept cool and used within 24 hours. Direct sunlight, excessive heat, or cold should be avoided.
Larval Therapy
Regular price
$139.00
Regular price
Sale price
$139.00
Unit price
per
Couldn't load pickup availability